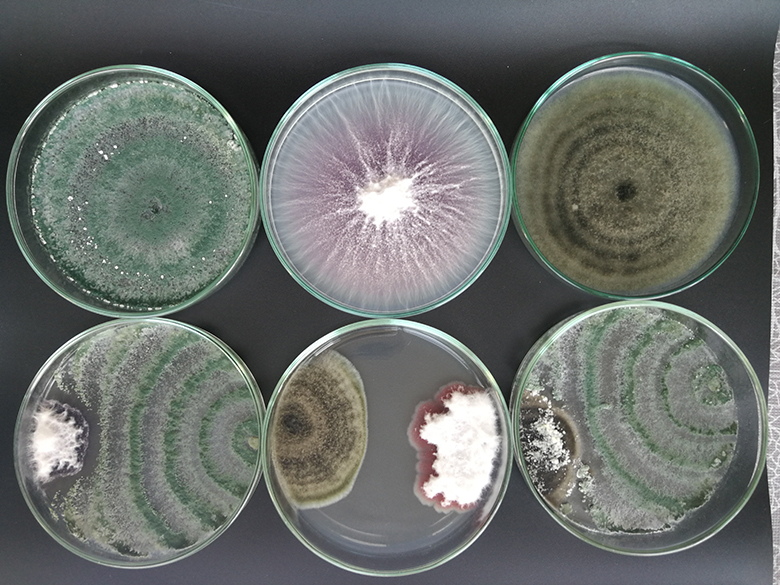
102 godine Agronomskog fakulteta

102 godine Agronomskog fakulteta
Povodom 102. obljetnice Agronomskog fakulteta bit će održana svečana sjednica Fakultetskog vijeća na kojoj će se dodijeliti nagrade i priznanja djelatnicima, znanstvenicima, nastavnicima i studentima
Agronomski fakultet Sveučilišta u Zagrebu sa 102 godine bogate akademske tradicije profilirao se kao vodeća znanstvena i sveučilišna ustanova u Hrvatskoj u području biotehničkih znanosti. Kroz bogatu povijest, fakultet se prilagođavao promjenama u visokom obrazovanju i znanosti kako bi primjenom najviših akademskih standarda omogućio studentima stjecanje kompetencija utemeljenih na suvremenim znanstvenim spoznajama i inovacijama.

Tijekom svih tih godina, nastavnici i znanstvenici Fakulteta bili su spremni odgovoriti na nove zahtjeve, izazove i prilike koje se postavljaju u znanosti i visokom obrazovanju.
Proizvodnja hrane, klimatske promjene, opća globalizacija u svijetu kao i aktualna pandemija još jednom su pokazali i opravdali društvenu važnost agronomije. Nastavnici i znanstvenici Agronomskog fakulteta kontinuirano nastoje oduševljenost i zaljubljenost u agronomiju prenositi budućim generacijama studenata i nastavnika, ali i steći razumijevanje cjelokupne hrvatske javnosti za struku.

Povodom 102. obljetnice Agronomskog fakulteta bit će održana svečana sjednica Fakultetskog vijeća na kojoj će se dodijeliti nagrade i priznanja djelatnicima, znanstvenicima, nastavnicima i studentima.
Svečana sjednica bit će održana 27. rujna 2021. godine u 11 sati. Zbog epidemiološke situacije na sjednici će prisustvovati samo nagrađeni, no cijela sjednica može se pratiti putem ZOOM-a
Meeting ID: 830 8456 2285